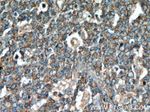
FAM13A Antibody in Immunohistochemistry (Paraffin) (IHC (P))

Search
Proteintech
FAM13A Polyclonal Antibody
{{$productOrderCtrl.translations['antibody.pdp.commerceCard.promotion.promotions']}}
{{$productOrderCtrl.translations['antibody.pdp.commerceCard.promotion.viewpromo']}}
{{$productOrderCtrl.translations['antibody.pdp.commerceCard.promotion.promocode']}}: {{promo.promoCode}} {{promo.promoTitle}} {{promo.promoDescription}}. {{$productOrderCtrl.translations['antibody.pdp.commerceCard.promotion.learnmore']}}
产品信息
55401-1-AP
种属反应
已发表种属
宿主/亚型
分类
类型
抗原
偶联物
形式
浓度
规格
纯化类型
保存液
内含物
保存条件
运输条件
产品详细信息
This antibody is specific to FAM13A. It can recognize all the isoforms of FAM13A.
靶标信息
FAM13A, also named as FAM13A1 and KIAA0914, belongs to the FAM13 family. It is associated with chronic obstructive pulmonary disease.
仅用于科研。不用于诊断过程。未经明确授权不得转售。
生物信息学
蛋白别名: FAM13A1_v2 protein; family with sequence similarity 13, member A1; Precm1 protein; Protein FAM13A; unnamed protein product
基因别名: AI462012; ARHGAP48; D430015B01Rik; FAM13A; FAM13A1; KIAA0914; Precm1
UniProt ID: (Human) O94988, (Mouse) Q8BGI4
Entrez Gene ID: (Human) 10144, (Mouse) 58909